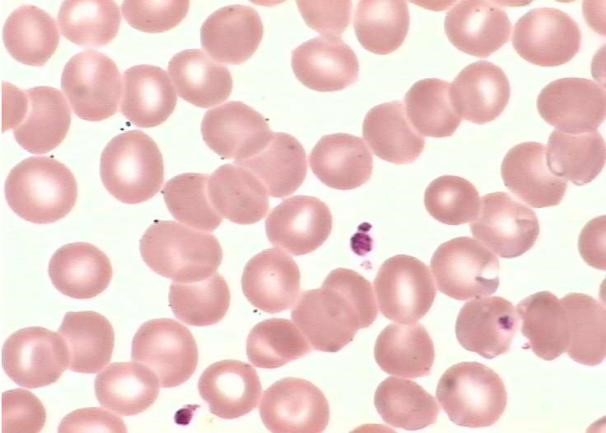
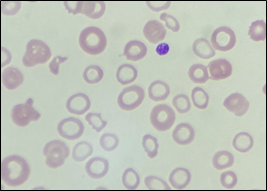
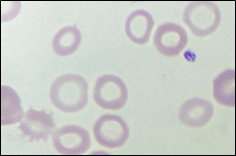
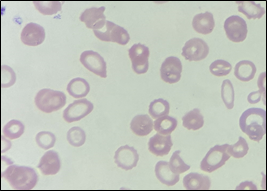
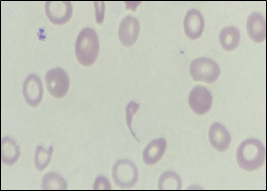
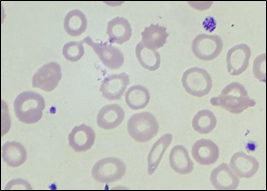
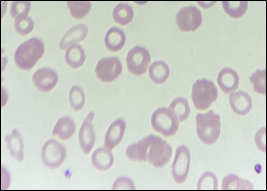

血色褪去的秘密日记
清晨的显微镜下,一份血涂片正在无声讲述着身体里的"铁荒"故事。28岁的患者小林的血样中,那些本该饱满如红石榴籽的红细胞,此刻却像被雨水反复冲刷的枫叶,褪去了鲜活的色彩。
第一幕:缩水的生命之舟
正常红细胞直径约7.8微米,如同精巧的飞盘。但在缺铁性贫血的世界里,这些"飞盘"集体缩水至6微米以下,相当于从壹元硬币退化成了纽扣电池。更令人揪心的是它们单薄的身躯——细胞厚度从常规的2微米削减到1.5微米,仿佛被压扁的铜锣烧。这种"小细胞低色素"的特征,是血红蛋白合成不足的无声呐喊。

正常红细胞 缺铁贫红细胞
第二幕:褪色的生命颜料
瑞氏染色剂将健康红细胞染成边缘橙红、中心淡粉的"靶环"造型,那是血红蛋白均匀分布的杰作。但在小林的血液里,这些细胞中心淡染区夸张地扩张,形成直径超过细胞1/3的苍白空洞,犹如被蛀空的月亮。当血红蛋白浓度跌破30g/L时,某些红细胞甚至变成透明的指环,只剩下边缘残留的淡红色细线。
环形红细胞
第三幕:变形的生存挣扎
在铁元素持续匮乏的压迫下,红细胞开始扭曲形态以求生存。涂片中可见:
- 椭圆形红细胞如同被拉长的橡皮糖
- 靶形红细胞像水上浮萍般漂移
- 泪滴状细胞拖着细长的尾巴
- 碎裂红细胞散落如红色星辰
这些形态各异的红细胞,实则是骨髓造血工厂的"赶工次品"——由于血红蛋白合成速度跟不上细胞分裂节奏,新生红细胞不得不在未装满"氧气货舱"的情况下提前启程。

红细胞各种异常形态
这些形态各异的红细胞,实则是骨髓造血工厂的"赶工次品"——由于血红蛋白合成速度跟不上细胞分裂节奏,新生红细胞不得不在未装满"氧气货舱"的情况下提前启程。
第四幕:中医视角的微观辨证
《黄帝内经》言:"中焦受气取汁,变化而赤为血。"在中医理论中,缺铁性贫血的微观世界正对应着"气血两虚"之证。涂片中疏朗分布的红细胞,恰似气血不足者"面白无华"的镜像;细胞边缘的锯齿状突起,暗合"血行不畅"的脉象。而当铁剂治疗见效时,新生的饱满红细胞又成为"健脾生血"理论的现代注脚。
第五幕:实验室的破译密码
1. 血常规报告单上的三组密码:
- MCV(平均红细胞体积)<80fl
- MCH(平均血红蛋白量)<27pg
- MCHC(平均血红蛋白浓度)<320g/L

实验室结果案例
2. 血清铁蛋白<15μg/L,如同身体发出的"铁储备告罄"警报
3. 骨髓铁染色中,幼红细胞内的铁颗粒消失殆尽,宛如被洗劫的粮仓
这些数据与形态学改变相互印证,织就诊断缺铁性贫血的严密证据链。
终章:血色重生的启示
当小林开始规律服用琥珀酸亚铁,配合猪肝与菠菜的食疗,显微镜下的红细胞世界悄然重焕生机。三周后的复查涂片中,新生红细胞带着饱满的弧度重返舞台,中心淡染区收敛成含蓄的月牙——这不仅是血红蛋白浓度回升的见证,更是生命系统自我修复的壮丽诗篇。
每一个褪色的红细胞都是身体书写的求救信,在实验室的方寸之间,我们读懂了这份用生命密码写就的铁质宣言。从微观形态到宏观健康,缺铁性贫血教会我们:有时治愈之道,就藏在最朴素的营养平衡之中。